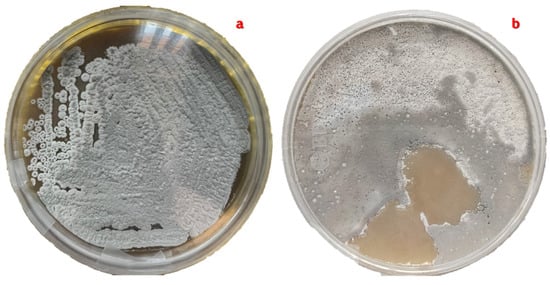
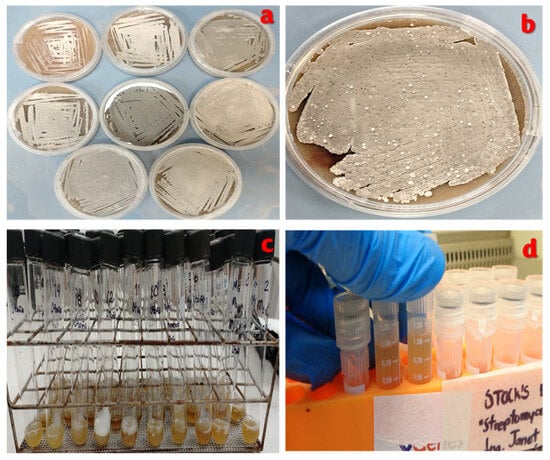

Abstract
Streptomyces avermitilis is a soil actinobacterium and has a complex metabolism in its natural habitat. Because of this, the environmental fluctuations present in the seasons can activate or silence the biosynthetic pathways involved in its metabolism. The objective of this research was to analyze the morphological characteristics of the metabolism of Streptomyces avermitilis, isolated during the four seasons of the year and from four types of soil. Isolation was performed on oat agar ISP-3 and nystatin as an antifungal agent. The planting methods were rod drag and cross striations. The Petri dishes were incubated for 10 days at 30 °C in complete darkness. For 10 days, a colony count was performed to analyze the growth curves, as was an evaluation of the diffusible pigments in each Petri dish. The isolates presented the diffusible pigments white, yellow, orange, red and pink with a higher proportion in spring and summer compared to in autumn and winter. Under laboratory conditions, the isolates in summer presented the three phases of bacterial growth: lag (24 h), exponential (48–96 h) and stationary (120–168 h). A doubling time of 35.30–62.92 h was obtained. The morphological characteristics of the metabolism of Streptomyces avermitilis show differences according to the climatic conditions of each season of the year.
1. Introduction
The seasonal evaluation of the metabolism of Streptomyces avermitilis in agricultural environments allows the identification of patterns in morphological and metabolic expression and active or silenced biosynthetic pathways, in addition to providing the ideal conditions to optimize its biotechnological activity. In this sense, the isolation of S. avermitilis and the biotechnological development of its main bioactive compounds in Mexico and the rest of the world represents an important advance in the treatment of health problems in Medicine, Veterinary Medicine and Agriculture, where the bioactive potential of the strain is fully exploited.
S. avermitilis is a soil actinobacterium of the Gram-positive type that presents a growth in filamentous, long and branched hyphae [1]. It shows two types of mycelia: the first is an aerial mycelium of cottony appearance with whitish to gray tones, and the second is imperceptible to the human eye [2,3]. The first usually appears during the exponential phase of the growth of the bacteria, while the second mycelium is underground and acts as a support to the substrate as a feeding conduit, taking the necessary nutrients provided by the culture medium; this usually appears in the last hours of the dormancy phase (lag phase). Under natural conditions, the growth of S. avermitilis in terrestrial soils is usually variable due to geographical conditions such as altitude and longitude, in addition to the type, shape and use of the soil, ecosystem where it develops, pH, humidity, and temperature [4,5]. According to these unique bacterial conditions, scientists have focused on harnessing S. avermitilis for its ability to produce biologically active compounds, some with antiparasitic, insecticidal (Ivermectin) or biological control-enhancing properties [1,2,3].
To achieve the potential of the species, it is necessary to study each phase that comprises its metabolism, which is why specific laboratory conditions are required to obtain the growth of S. avermitilis. These conditions include the type of culture medium, an optimal temperature range, the pH of the medium and the type and manner of bacterial seeding. These factors together present variations in the morphology and form of metabolism in S. avermitilis [4,5,6].
A key point for determining the morphological characteristics of the species is to use a culture medium that provides the necessary nutrients. For the bacterial growth of S. avermitilis, a culture medium rich in carbon and nitrogen (oat agar, malt extract agar, yeast extract agar and starch) is required; a broad-spectrum antibiotic must be used as an antifungal agent to avoid nutrient competition between other microorganisms [5]. In addition, the main matter of the medium must provide a strong substrate to act as a secure anchoring system, so that the species can develop its underground mycelium. This species grows at a temperature between 25 °C and 32 °C [7,8] inside an incubator in complete darkness for 15 days [4,5,7].
In addition to this, the metabolism of S. avermitilis presents different morphotypes when performing several repetitions in the planting in Petri dishes, in which colonies of different sizes, variations in the amount of mycelium and different diffusible pigments usually appear. This occurs because the same strain of S. avermitilis behaves differently due to the interaction of factors controlled in the laboratory, such as temperature, humidity and pH of the culture medium, where the bacterial isolation is carried out [6].
As S. avermitilis is a microorganism that requires extreme care during its growth and isolation [9], it is necessary to use appropriate planting techniques that allow the correct expression of the species; it is recommended to use techniques such as rod dragging to observe the production of diffusible pigments [10], while cross-striation seeding is useful in the purification of bacterial cultures or in making a collection of bacterial strains in Petri dishes [11].
In accordance with the above, the objective of this research was to evaluate the morphological characteristics that occur in the metabolism of S. avermitilis, for which it was established that the isolation of the species was from four types of soil with different agricultural uses (soil with crops, soil in a resting state, soil of a silvopastoral system and soil from a dairy shed). The use of light during bacterial growth and fermentation of the species to obtain Ivermectin was also controlled.
To obtain reliable results and have greater repetition of each phase, the research model was carried out over the four seasons of the period 2024–2025, so that S. avermitilis would provide more information about its metabolism; this, in turn, served as a basis for analyzing the possible adaptations of each morphological characteristic as a response to the different climatic conditions of each season.
2. Materials and Methods
2.1. Geographical Conditions
Four areas with different land uses during the four seasons of the year (2024–2025) were evaluated at the facilities of the Colegio de Postgraduados, Montecillo Campus, Texcoco de Mora, State of Mexico, Mexico, with the following coordinates 19°27′38″ N and 98°54′11″ W at an altitude of 2250 m.a.s.l., and an average annual rainfall for the period 2024–2025 of 924.7 mm. The monitoring of climatic conditions, such as temperature, humidity and precipitation during the four seasons corresponding to the period 2024–2025, was carried out based on the Merra-2 model on the WeatherSpark.com platform with a confidence level of 95%.
2.2. Collection and Processing of Soil Samples
The four soils selected to obtain an isolation of S. avermitilis at the facilities of the Colegio de Postgraduados, Campus Montecillo, were identified as follows: M1 (soil with oat and corn cultivation), M2 (soil at rest), M3 (soil of a silvopastoral system) and M4 (soil of a dairy shed). From each area, 5 kg soil samples were collected with zig-zag sampling, for which it was necessary to remove the first 15 cm of each floor with a sterile shovel; subsequently, the previously identified samples were placed inside Ziploc® polyethylene bags, which were hermetically sealed. The samples were stored in a personal cooler at 4 °C for transport to the Animal Nutrition Laboratory of the same institution.
Each soil sample was homogeneously mixed on a stable, smooth surface to obtain a composite soil sample, followed by taking 2 g of each soil sample, which was then dissolved in 10 mL of 0.1% sterile peptonated water: 1.0 g L−1 peptone (MCD Lab, Cat. 9072, Tultitlán of Mariano Escobedo 54900, Mexico) and 8.5 g L−1 NaCl (Merck, Art. 21578, Darmstadt 64293, Germany) [5,12]. Once dissolved, they were stirred in a vortex at full speed for 20 s.
Finally, serial dilutions of 10−1 to 10−10 were performed; of these, dilutions of 10−4, 10−5 and 10−6 were used for planting by rod dragging in Petri dishes [13].
2.3. Preparation of the Specific Culture Medium: Oatmeal Agar ISP-3 + Nystatin
The specific culture medium used in the isolation, purification, and characterization of S. avermitilis was ISP-3 oatmeal agar medium [14,15]: 60.0 g L−1 of previously screened oat flour and 12.5 g L−1 of bacteriological agar (MCD Lab, Cat. 9012, Tultitlán of Mariano Escobedo 54900, Mexico), supplemented with 1% nystatin (100,000 IU mL−1, Alpharma® Mexico City 02300, Mexico) [5,10,13,16,17].
The initial components were homogeneously mixed and added to a glass bottle with a screw lid with approximately 700 mL of distilled water at a temperature of 305 °C for 30 min, stirred by a magnetic plate stirrer (Velp scientifica®, Arec. T, Deer Park, NY, USA) at a stirring speed of 1500 rpm. After 30 min, nystatin (1%) was added, and 300 mL of distilled water was added to finish dissolving the components completely.
It was then allowed to boil for one minute; the bottle was covered with the screw cap and autoclaved at 121 °C for 15 min.
Finally, the oatmeal agar ISP-3 culture medium supplemented with nystatin was emptied into sterile polystyrene Petri dishes of 90 × 15 mm (Klinicus®, Lot 240903, Mexico City 02700, Mexico) inside a bacteriological hood, type A2 (Thermo Scientific®, Model 1385 Rel 2, Waltham 02451, MA, USA), previously sterilized with ethyl alcohol at 96° (AZ® Zapopan, Jalisco 45235, Mexico) and concentrated red antibenzyl (Pharmaceutics Altamirano®, Lot 24-333L, Mexico City 01180, Mexico).
2.4. Initial Seeding and Purification of the Streptomyces avermitilis Strain in a Dish
The initial bacterial seeding technique was rod dragging. In the ISP-3 oatmeal agar Petri dishes, 100 μL of each of the working dilutions (10−4, 10−5 and 10−6) was deposited in triplicate. The Petri dishes were sealed with parafilm paper and stacked so that the initial inoculum was absorbed by the culture medium (approximately 15 min). When the surface of the medium in the Petri dish was no longer wet, they were placed upside down inside an incubator at 30 °C in complete darkness for 10 days.
For the pure culture of S. avermitilis in solid medium, the previous medium (ISP-3 oatmeal agar and 1% nystatin) was subcultured, and 500 μL of enzyme α-amylase was added. The technique used for this culture was bacterial cross-striation seeding [18]. On the other hand, for the pure culture in liquid medium, a medium based on Trypticacasein Broth (CTS, DIBICO, Cat. 1186-E Cuautitlán Izcalli 54730, Mexico) supplemented with glucose was used: 17.0 g L−1 of casein peptone, 3.0 g L−1 of soy peptone, 5.0 g L−1 of NaCl, 2.5 g L−1 of K2HPO4 and 2.5 g L−1 of glucose (Meyer, Cat. 1440, Matamoros, 58240 Morelia, Michoacan, Mexico).
Samples of S. avermitilis in liquid medium were incubated for 10 days in an incubator in complete darkness at a temperature of 30 °C.
After the incubation process was completed, 850 μL of the liquid culture of S. avermitilis was taken, and 150 μL of sterile glycerol was added. This mixture was stored in 2 mL tubes with screw caps (SSIBIO, Cat. 50236, CA 95240, USA), then mixed in a vortex for 30 s. Finally, each tube was identified by soil type and season of the year, and they were deposited in the freezer at −20 °C for the conservation of the species and for subsequent analysis.
During the 10 days of incubation, bacterial counts were performed each day. These data were useful to analyze the bacterial growth curves, the presence of aerial mycelium and the production of diffusible pigments.
2.5. Catalase Test
A sample of the aerial mycelium of S. avermitilis was taken on the seventh day of incubation and placed on a slide; 250 μL of 3.5% surgical-grade hydrogen peroxide (Alcomex®, Mexico City 06800, México) was added and spread over 80% of the slide surface.
A positive reaction was considered to be when bubbling was observed over the sample [19].
2.6. Gram Stain
A sample from a pure colony of S. avermitilis was mounted on a coverslip and diluted with sterile distilled water to form a smear. The smear was fixed with exposure to the non-luminous flame of a lighter for 30 s. Subsequently, 200 μL of gentian violet dye (Hycel®, Cat. 6269, Zapopan 45190, Jalisco, Mexico) was added and left on for one minute and then rinsed with tap water and allowed to drain (no drying with sterile paper was necessary). Next, 200 μL of the dye Iodine Gram (Hycel®, Cat. 724, Zapopan 45190, Jalisco, Mexico) was added, allowed to stand for a minimal time and washed again directly with tap water. In addition, 200 μL of alcohol-acetone (Hycel®, Cat. 901, Zapopan 45190, Jalisco, Mexico) was added for 5 s, washed directly with tap water and allowed to drain.
Finally, 200 μL of the dye Safranin (Hycel®, Cat. 826, Zapopan 45190, Jalisco, Mexico) was added, allowed to stand for one minute, washed with a direct stream of tap water and dried with sterile paper. An observation was made under an optical microscope (Lobmed CxL, Fremont, CA 94538, USA) at 100x with immersion oil.
If the sample was stained pink/fuchsia, the bacteria were Gram−, if the sample was stained blue/purple, the bacteria were Gram+ [20].
2.7. Validation Analysis: HPLC Analysis
2.7.1. Initial Inoculum
A total of 2 g of pure culture of S. avermitilis was transferred to an oat-based liquid medium. Half of the oats were composed of 10.0 g L−1 oat flour, 4.0 g L−1 glucose (D-glucose, anhydrous, Meyer, Cat. 1440), 4.0 g L−1 yeast extract and 2.0 g L−1 CaCO3 (J.T. Baker Cat. 1288, Alcobendas 28108, Madrid, España). The inoculum temperature was maintained at 25 °C, with a final pH of 6.56.
Finally, this mixture was dissolved for 1 h in a stirring flask with a capacity of 250 mL. The incubation time in a bain-marie was 24 h at a speed of 1500 rpm in a magnetic plate stirrer (Velp scientifica®, Arec. T.).
2.7.2. Submerged Batch Fermentation (SmF) of Streptomyces avermitilis
The liquid medium was composed of 50.0 g L−1 soluble corn starch (Maizena®, Cat. 69571779, Mexico City 05120, Mexico), 500 μL α-amylase enzyme (Thermozyme L-340, Enmex S.A de C.V, Tlalnepantla 54030, Mexico), 0.8 g L−1 CaCO3 (J.T. Baker, Cat. 1288, Alcobendas 28108, Madrid, España), 0.1 g L−1 KCl (Merck, Cat. 4936, Darmstadt 64293, Germany), 2.0 g L−1 yeast extract, 0.1 g L−1 MgSO4·7H2O (J.T. Baker, Cat. 2500, Alcobendas 28108, Madrid, España) and 0.5 g L−1 NaCl (Merck, Cat. 21578, WGKO 722-2, Darmstadt 64293, Germany); 10% of the initial inoculum (v/v, fraction a) was added to this enriched medium, which was then mixed at 1500 rpm in a magnetic plate stirrer (Velp scientifica®, Arec. T) [5].
This medium was placed inside fermentation flasks in discontinuous culture (closed flasks). Submerged fermentation was carried out in a double boiler in complete darkness for 10 days at 25 °C and a stirring speed of 1500 rpm.
2.7.3. Ivermectin B1b Extraction
The bacterial broth resulting from fermentation immersed in complete darkness was centrifuged at 4 °C (cold chain) for 20 min at 8000× g. In this first centrifugation process, the pellet containing the cell biomass was obtained, where Ivermectin B1b (intracellular molecule) was found. The pellet was evenly mixed with 12 mL of HPLC-grade methanol (J. T. Baker, Cat. UN1230, Alcobendas 28108, Madrid, España) until it was dissolved and centrifuged again under the conditions described above.
The new supernatant was collected in 50 mL amber vials for Ivermectin analysis by HPLC with UV-Vis.
2.7.4. Chromatographic Conditions for HPLC-UV Vis
To analytically corroborate the presence of the secondary metabolite Ivermectin, a high-performance liquid chromatograph (HPLC, Perkin Elmer, serves 200, Waltham 02451, Massachusetts, USA) coupled to a UV-Vis detector (Perkin Elmer, Waltham 02451, MA, USA) was used. The chromatographic method for HPLC used in this analysis is listed in Table 1.

Table 1.
Analytical conditions for chromatography in HPLC.
The mobile phase was composed of acetonitrile (ACN, Merck, Cat. AX0145-1, Darmstadt 64293, Germany)/HPLC-grade water (H2O, J. T. Baker, Cat. 4218-03, Alcobendas 28108, Madrid, España) at a v/v ratio of 80:20%. This phase was passed through a vacuum system composed of a funnel beaker (Kimax®, Rockwood, TN 37854, USA), a 0.22 μm nylon filter (Thermo Scientific®, Waltham 02451, MA, USA), a 1000 mL Kitasate flask (Kimax®, Rockwood, Tennessee 37854, USA), an aluminum clamp and a ½ inch diameter transparent hose that was connected to the vacuum pump.
2.8. Statistical Analysis
Each variable was analyzed with the SAS program, version 9.4 (SAS Institute, Inc., Cary, NC 27513, USA), using a completely randomized block design (four blocks—seasons of the year—with four treatments—M1, M2, M3 and M4—and three replications).
The data was used to perform an analysis of variance (ANOVA), a test of normality and one of slope homogeneity. The means per treatment and per block were compared with a Tukey test (α = 0.05).
3. Results
3.1. Behavior in Meteorological Conditions for the Period 2024–2025
The determination of the climatological variables (temperature, precipitation and humidity) during the four seasons corresponding to the period 2024–2025 was carried out based on the Merra-2 model on the WeatherSpark.com platform with a confidence level of 95%.
Figure 1a shows the maximum, minimum, and average temperature levels for each month, including seasonal data. The gray bars correspond to the daily temperature ranges, the red lines represent the maximum temperatures and the blue lines mark the minimum temperatures recorded.

Figure 1.
Weather conditions in Texcoco de Mora, Mexico, during the seasons of the period 2024–2025. (a). Maximum, minimum and average temperatures for each month of the corresponding season. (b). Precipitation levels per month for each corresponding station. (c). Humidity levels per month for each corresponding season.
Figure 1b shows the precipitation levels for Texcoco de Mora, Mexico, during the four seasons of the period 2024–2025, where the observed time per hour is color-coded according to the category in order of intensity, while Figure 1c presents the humidity levels during the same seasons of the 2024–2025 period. In this subsection it can be seen that the criterion used to classify the humidity level was the recorded daily dew point. The gray stripes indicate the period corresponding to the night and civil twilight.
According to the climatic conditions previously analyzed, it was determined that the area where the samples were taken presented the optimal conditions for the development of S. avermitilis. It should be noted that the isolation of S. avermitilis can be complex due to the direct effect of climatic conditions on each soil sample. This occurs due to anomalies present in the climate of each season of the year (increases or decreases in temperature, humidity and precipitation).
All of this together has a negative impact on the frequency with which S. avermitilis bacterial cells form their characteristic filamentous hyphae and colonies in the specific culture medium at the laboratory level.
This is due to a slow or accelerated bacterial metabolism, so important bacterial characteristics are not clearly visible.
3.2. Culture Medium Yield: Oatmeal Agar ISP-3
The International Streptomyces Project (ISP) [15,16] describes at least eight specific culture media for the isolation, characterization and purification of strains of the genus Streptomyces, within which the ISP-3 medium, oatmeal agar, allows the correct specific morphological characterization of S. avermitilis.
In this study, the culture medium was made in an artisanal way with oat flakes (Figure 2).

Figure 2.
Procedure for the production of the ISP-3 oatmeal agar culture medium. (a). Base materials for the elaboration of specific medium. (b). Weighing oats and nystatin. (c). Mixture of all components, (d). Stirring on magnetic plate stirrer. (e). Pouring oatmeal agar into a Petri dish. (f). Gelled oatmeal agar with ISP-3 culture medium.
Table 2 shows the technical information of the ISP-3 oatmeal agar culture medium supplemented with nystatin as an antifungal agent, which was laboratory tested for use in isolates and purifications of the strain.

Table 2.
Conditions for quality control and microbiological testing on ISP-3 oatmeal agar.
This specific culture medium is useful in isolating and purifications of S. avermitilis because it allows the formation of filamentous spores and hyphae. The production of diffusible pigments works as an ideal substrate for the storage of the strain, both in plate and in liquid medium, where a shelf life is maintained after 12 weeks.
3.3. Morphological Characterization of Streptomyces avermitilis
The morphological characteristics of the pure strain isolated by the two types of seeding during the four seasons of the year were used in detail for the taxonomic classification of S. avermitilis (Figure 3). This analysis was performed using the taxonomic keys proposed in the Bergey Manual, Volume 5: “Actinobacteria” [21,22].
Figure 3.
Pure cultivation of S. avermitilis with cotton-like aerial mycelium in gray tones. (a). Pure culture product of the cross-striation technique with four quadrants. (b). Pure culture obtained with the rod dragging technique.
3.3.1. Species-Specific Taxonomic Key Streptomyces avermitilis
Group 3. Spiral formation in the aerial mycelium: long, open spirals (Figure 4).

Figure 4.
Aerial culture of mycelium and pure colony of S. avermitilis isolated in oatmeal agar (ISP-3).
I. Saprophytes; Psychrophile physician for mesophiles.
B. Presence of soluble pigments in brown tones in organic growing media.
1. Dark brown pigments (chromogenic type).
A7. Cream to dark brown growth; gray aerial mycelium; sporophores in groups.
48. Streptomyces avermitilis [2,21,23,24,25].
Synonyms:Streptomyces antibioticus [26], Streptomyces avermectinius [27], Actinomyces antibioticus [2].
Both crops are planted on ISP-3 oatmeal agar supplemented with nystatin.
3.3.2. Characteristics of Mature Hyphae
Sporulation of S. avermitilis bacteria occurred in the culture medium of ISP-3 oatmeal agar supplemented with 1% nystatin. On the seventh day of incubation in complete darkness at a temperature of 30 °C, the pure culture reached its peak maturity, as 95% of the plate cultures had cotton-like aerial mycelium in shades of gray and white (Figure 3, Figure 4 and Figure 5).

Figure 5.
Presence of cotton-like aerial mycelium in whitish tones. (a). Spread of the mycelium throughout the culture plate. (b). Central mycelium.
The effects of total incubation time (10 days) added to those of abiotic stress (incubation in complete darkness) and the use of ISP-3 oatmeal agar + 1% nystatin medium as a specific medium for the identification of S. avermitilis. This effect allowed the bacterium to activate the sporulation phase between day five and seven.
The filamentous hyphae of the bacterium S. avermitilis were observed using the Gram staining technique. In addition, verification was carried out by microscopic visualization at 40x and 100x (Figure 6 and Figure 7).

Figure 6.
Observation of the smear of S. avermitilis with 40× magnification in an optical microscope. You can see the large network of filamentous hyphae characteristic of the strain; they will always be arranged in long whorls where the spores are located.

Figure 7.
Gram stain on the smear of S. avermitilis seen at 40× magnification under an optical microscope. The final coloration was blue/purple, indicating that S. avermitilis is a Gram+ microorganism.
3.3.3. Morphological Differences in Streptomyces avermitilis Isolates Evaluated over the Four Seasons of the Year
Throughout the isolations carried out during the four seasons of the year, some important changes were observed, such as the presence of growth morphotypes of S.s avermitilis in the plates with the oatmeal agar medium ISP-3 and the production of various diffusible pigments. Figure 8 clearly shows these differences.

Figure 8.
Morphological and color differences in S. avermitilis evaluated over the four seasons of the year.
These differences present in S. avermitilis are usually related to increases in soil pH (natural conditions, Table 3) or culture medium (in vitro). This change can be caused by the bacterium itself when it self-induces an increase in extracellular pH as a defense against predators, or a change in the pH of the medium occurs due to exogenous alkaline compounds (carbonate-rich water, fertilizers, pesticides, contaminated water) [28].

Table 3.
pH conditions of the four types of land use during each season of the year.
3.4. Maintenance of Streptomyces avermitilis
The collection of bacterial strains of the species is under the supervision of the Animal Nutrition Laboratory of the Colegio de Postgraduados, Montecillo Campus.
S. avermitilis isolates from four different soil types and extracted during the four seasons of the year were purified in two types of presentation. The first presentation is a plate deformation with two different types of seeding, cross striations and rod drag (Figure 9a,b).
Figure 9.
Collection of bacterial strains of the species S. avermitilis. (a). Strain with cross-groove seeding in the medium of ISP-3 oatmeal agar. (b). Compilation of S. avermitilis with rod dragging sowing in medium oatmeal agar ISP-3. (c). Compilation of S. avermitilis in CTS in glass tubes cooled to 4 °C. (d). Collection of S. avermitilis in glycerol at 15% at −20 °C.
3.5. Production of Diffusible Pigments
As described at the Microbiology Workshop in Montreal, Canada [29], S. species have the ability to produce a series of 10 colors on a specific substrate in vitro. These colors are white, yellow, orange, red, pink, purple, coffee, wine, gray, and black.
In this analysis, the presence of these 10 colors was measured daily for 10 days in each of the isolates during the four seasons of the year (Figure 10).

Figure 10.
Pigments produced by S. avermitilis by type of land use during the four seasons of the year.
The production of diffusible pigments of S. avermitilis in the four soil types (M1, M2, M3 and M4) in spring resulted in a greater presence of the following colors: white (33.33%, 66.67%, 88.89% and 44.44%), yellow (46.67%, 66.67%, 100% and 88.89%), orange (23.33%, 22.22%, 11.11% and 22.22%), red (33.33%, 100%, 44.44% and 66.67%) and pink (13.33%, 11.11%, 22.22% and 11.11%). The colors that had the lowest presence were purple (presence only in M3 with 11.11% and in M4 with 11.11%), wine (presence only in M1 with 23.33% and in M4 with 33.33%), brown (only in M1 with 12.22%), gray (presence only in M1 with 12.22%, M2 with 22.22% and M4 with 11.11%) and black (presence only in M4 with 11.11%).
In the summer, the colors with the highest presence were white (33.33%, 44.44%, 33.33% and 11.11%), yellow (100%, 77.78%, 66.67% and 66.67%), orange (22.22%, 11.11%, 33.33% and 22.22%) and red (55.56%, 33.33%, 66.67% and 77.78%). The lowest presences were purple (with presence only in M2 with 11.11%), gray (11.11% in M1 and 22.22% in M4) and black (11.11% in M1 and 11.11% in M4), while the absent colors were pink, wine and brown.
In autumn, the greatest presence was concentrated in white (88.89%, 66.67%, 66.67% and 66.67%), yellow (88.89%, 55.56%, 66.67% and 100%), orange (11.11% in M1, M2 and M3) and red (55.56%, 44.44%, 66.67% and 55.56%). The lowest presence was only gray (33.33% in M1 and 11.11% in M4); those that did not manifest were pink, purple, wine, brown and black.
Finally, in winter, the highest presence of pigments was white (77.78%, 77.78%, 88.89% and 66.67%), yellow (66.67%, 66.67%, 88.89% and 44.44%), orange (only 11.11% in M2) and red (55.56%, 33.33%, 77.78% and 55.56%). Only black had low presence (11.11% in M2 and M4), and the missing pigments were pink, purple, wine, brown and gray.
The behavior of the diffusible pigments presented in S. avermitilis, isolated from soils with different agricultural uses, was mainly due to climatological conditions and not to the type of soil where the bacterium was isolated.
The biotic stress used in this analysis was the climatological conditions of each season of the year (Table 4).

Table 4.
Environmental conditions of the seasons for the period 2024–2025 in Texcoco de Mora, Mexico.
So, when there are environmental fluctuations, S. avermitilis can activate its biosynthetic pathway of the polyketid PNKs responsible for secreting these various colors as a defense and survival mechanism [12,30,31,32].
3.6. Bacterial Growth of Streptomyces avermitilis During the Four Seasons of the Year
In order to know the behavior of the metabolism of S. avermitilis, it was necessary to construct bacterial growth curves, in order to analyze its metabolism in the four types of soil evaluated over the four seasons of the year. These charts are a basic tool in the manipulation of bacterial metabolism, as they help to enhance the development of secondary metabolites of S. avermitilis [33,34].
In the spring, the bacterial growth of S. avermitilis presented the exponential phase with a duration of 72 h and the stationary phase with a duration of 168 h (Figure 11). This behavior was the same in all four soil types during the 10 days of incubation in complete darkness.

Figure 11.
Bacterial growth behavior of S. avermitilis over 10 days in the spring.
In the summer, the bacterial growth of S. avermitilis of the four soil types had the same behavior as the three phases of bacterial growth (lagging, exponential and stationary phase; Figure 12). The lagging phase lasted 24 h in the four soil types, the exponential phase was 48 h in M1 and M4, while in M2 and M3 it was 96 h. The stationary phase lasted 168 h in M1 and M4, and 120 h for M2 and M3.

Figure 12.
Bacterial growth behavior of S. avermitilis over 10 days in the summer.
Due to a slight decrease in temperature, precipitation and moisture present in the autumn, the bacterial growth phases of S. avermitilis showed notable changes in three of the four soil types (Figure 13).

Figure 13.
Bacterial growth behavior of S. avermitilis over 10 days in the autumn.
For this reason, soil types M1, M3 and M4 only presented two phases of bacterial growth: the exponential phase lasted 96 h while the stationary phase lasted 144 h.
However, in soil type M2, all three phases of bacterial growth were present. The delay phase lasted 24 h, the exponential phase lasted 120 h and the stationary phase lasted 96 h.
In the winter, the metabolism of S. avermitilis showed unusual behavior, since in M1, M2 and M3, the exponential phase and the stationary phase lasted 120 h each (Figure 14). In M4 the three phases of bacterial growth were present, where the delay phase lasted 24 h, the exponential phase lasted 120 h and the stationary phase lasted 96 h.

Figure 14.
Bacterial growth behavior of S. avermitilis over 10 days in the winter.
3.7. Bacterial Doubling Time
The bacterial doubling time results for S.s avermitilis with ISP-3 oatmeal agar and 1% nystatin medium Petri dish growth were calculated based on daily Petri dish counts at the same time.
The counts were transformed into a natural logarithm (Ln) and then plotted using linear regression and mu (the slope of the line representing the linear model and expressing the number of cells h−1 in the exponential phase, Table 5).

Table 5.
Doubling time of S. avermitilis by type of soil, expressed in hours.
3.8. Concentration (μg mL −1) of Ivermectin B1b Produced over the Four Seasons of the Year
High-performance liquid chromatography (HPLC) revealed the presence of Ivermectin B1b [5,13,35,36] in the four isolates of soils with different agricultural uses evaluated during the four seasons of the year.
It is confirmed that S. avermitilis produces its main secondary metabolite in all seasons of the year and that the total concentration depends on the temperature, humidity and precipitation of the corresponding season; likewise, the correct activation of the biosynthetic pathways within the secondary metabolism of S. avermitilis will be mediated by the type of land use of the isolate.
Several studies have shown that the climatic factor produces three main constraints on the production of secondary metabolites in S. avermitilis: poor performance in the production of the metabolite, retardation of bacterial growth, and difficulties in activating biosynthetic pathways for the production of secondary metabolites [6,34,37,38,39,40].
The highest concentration of Ivermectin B1b produced through submerged fermentation (Table 6) occurred in the summer season (820.71 ± 132.67 μg mL−1), while the isolate that produced the highest concentration of Ivermectin B1b throughout the four seasons of the year was M4 (dairy barn floor).

Table 6.
Total concentration (μg mL−1) of Ivermectin B1b produced over the four seasons of the year with four isolations from soils for agricultural use.
3.9. Retention Time (min) of Ivermectin B1b Analyzed over the Four Seasons of the Year
The retention time is a unit of time measured in minutes, provided by the chromatogram in HPLC. It has no direct relationship with the area under the curve and the total concentration of Ivermectin B1b; it simply serves to indicate at what minute the concentration peaks occur.
Some studies have reported that the maximum peak corresponding to Ivermectin B1b occurs at 4.32 min [35], 7.73 min [41], 10.08 min [42], 12.54 min [5,13] and 19.94 min [43]. Therefore, the results obtained here (mean retention time: 7.355 min, Figure 15) are within the range established by other authors (Table 7). This response is due to the type of mobile phase and column used in the analytical method for HPLC.

Figure 15.
HPLC chromatogram of the soils of the samples. The highest peak corresponding to Ivermectin B1b was observed with a retention time of 7.355 min.

Table 7.
Retention time read with high-performance liquid chromatography (HPLC) for Ivermectin B1b analysis.
4. Discussion
4.1. Effect of the Proposed Model
This research carried out the evaluation of the morphological characteristics present in the metabolism of S. avermitilis isolated from four soils with different agricultural uses over the four seasons of the year for the period 2024–2025 at the Colegio de Postgraduados, Campus Montecillo, Texcoco de Mora, State of Mexico, Mexico. The purified isolates of S. avermitilis used in this research come from terrestrial soils, specifically from different land uses: soil with forage crops (oats and corn), resting soil (>5 years), soil of a silvopastoral system (Cajanus cajan) and the floor of a dairy barn. The design of the present research allowed the analysis of temperature, precipitation and humidity over the four seasons in the period 2024–2025 in the same sites where the soil samples were collected.
Based on this proposed model, exact values were obtained on the proportion of diffusible pigments by season of the year and by land use, the duration of the bacterial growth phases, the morphological differences in the species and the different morphotypes that occurred in the three concentrations used in each planting (10−4, 10−5 and 10−6) that were described in other studies conducted with the same species [13,25,44].
This shows that different types of soil, regardless of their use, present strains of S. avermitilis with great biosynthetic potential [45]; the same effect was found with S. avermitilis isolated in Japanese soils [5,7,25,45].
Various studies mentioned that in the 70s, the presence of the species was possibly due to the result of the multiple mutations found in soil microorganisms after the atomic bombing in the cities of Hiroshima and Nagasaki [13,22,23,24,25,27,38,44,46,47,48]. According to the findings, it is shown that S. avermitilis is a microorganism present in any type of soil regardless of the use applied to it, and that it can be found in Mexican soils.
4.2. Factors Involved in the Metabolism of Streptomyces avermitilis
When performing the analysis of some characteristics of the bacterial metabolism of S. avermitilis, it is necessary to know the climatic conditions of the area where the collection of soil samples and the subsequent isolation were carried out. This is intended to respond to the behavior of the species observed in laboratory conditions, with respect to the climatic conditions that the area presented when the sample was collected (Table 4, Figure 11, Figure 12, Figure 13 and Figure 14).
In addition to this, and according to what was presented in this research, the main climatological variables that influence the characterization of the bacterial metabolism of S. avermitilis are temperature, precipitation and humidity, since the species’ presence in the four soils with different agricultural use depended on them. These variables also influenced the production of metabolites with biosynthetic potential that were evaluated. This premise was also reported in a study on the production of secondary metabolites in species of the genus Streptomyces [37].
Another surprising result of this research was that the climatological variables analyzed during the period 2024–2025 (a very rainy and hot period according to the Merra-2 model) were related to the presence and duration of each of the phases of bacterial growth of S. avermitilis in every season of the year. For example, the most outstanding season, with a growth almost identical to what the literature indicates, was summer, when there was a temperature of 28 °C, a rainfall of 133 mm and 60–70% humidity, which gave the species the necessary tools to produce this response.
On the other hand, bacterial growth is a physiological variable of bacteria, and in the case of S. avermitilis, this will depend on the climatological conditions of the season in which the soil sample has been collected for isolation [9]. This is due to the way it responds to the amount of nutrients available in the soil, bacterial competition, plant roots capturing higher moisture, temperature, pH, and the availability of carbon/nitrogen in the substrate [1,4,5,7,9,13,44]. According to the previous levels, the three most important phases of bacterial growth, based on what was established in other studies [2,11], the lag phase, the exponential phase and the stationary phase, were present and were analyzed according to the type of soil and by season of the year to present the exact duration, which had not been reported until now.
4.3. Optimal Bacterial Growth Conditions for Streptomyces avermitilis
According to previous research [1,5,7,13], it has been proven that S. avermitilis can develop in sites with temperatures of 12 °C to 30 °C and with a minimum of 10% humidity, as these conditions allow the perfect balance between the substrate, nutrients, bacteria and the activation of the main BGC [25,38]. With this approach, the metabolism of S. avermitilis was analyzed for the first time over a longer period of time compared to other studies, where the maximum duration recorded was 15 days [1,3,4,5,7,13,17,49].
Returning to what was explained in the International Streptomyces Project (ISP 2.0), growing under laboratory conditions with a culture medium such as oatmeal agar is possible and is cataloged within the four specific media for species of the genus Streptomyces. For the in vitro analysis, improvements in techniques and strategies were proposed in order to ensure the correct expression of secondary metabolites (diffusible pigments, filamentous hyphae, spores). Therefore, oatmeal was used in this research to obtain the ISP-3 oatmeal agar culture medium. This was produced by grinding previously sifted oat flakes, equivalent to a rich, abundant, and balanced source of carbon/nitrogen (3:1) [15,44]. Oatmeal was used for its ease of acquisition, as well as for its high content of proteins and natural nutrients, which are required during the bacterial growth of S. avermitilis [5,7,13,50]. Oatmeal agar supplemented with 1% nystatin as a finished product is usually an easy culture medium to prepare and handle, which represents an economic advantage and gain in laboratory time [37].
The specific culture medium developed for the identification, isolation and purification of S. avermitilis offers a practical and sustainable solution that is able to compete with the culture media available on the market, making it an accessible raw material to perform laboratory techniques in Microbiology.
4.4. Bacterial Growth of Streptomyces avermitilis
Some studies mention that the peak of sporulation and formation of the filamentous hyphae of S. avermitilis occurred on day 15 [5,13,46], while the strain used in this study showed its sporulation between day 5 and 7 of the exponential phase of its bacterial growth. This occurred in response to induced abiotic stimulation (growth in complete darkness) and the correct assimilation of nutrients provided in the ISP-3 oatmeal agar medium under laboratory conditions [49], as S. avermitilis activated its metabolism to survive under controlled light conditions during incubation time. This behavior is characteristic of S. avermitilis; therefore, by presenting a genome with at least 38 BGC for the production of secondary metabolites [33,37,38], these can be activated or deactivated in those seasons of the year where the amount of nutrients in the soil or in the growing medium is depleted or skyrockets.
However, the bacterial doubling time of a species is associated with the rate at which its primary metabolism takes advantage of the available nutrients [9,51] to be transformed into energy for the bacterium, achieving the activation of secondary metabolism and thus obtaining the biologically active products (secondary metabolites) [11,33,37,38,52].
Regarding the doubling rate derived from the growth phases of S. avermitilis, the comparison was made with several studies to establish if the parameters obtained in this research were within the expected range. Found in a study on the development of native antibiotic pathways for growth manipulation in strains of Streptomyces sp., a rapid replication rate of 3.6 h was obtained [47]; another study revealed that the doubling rate in species of the genus Streptomyces can range from 6.5 h to 5.6 days [53]. On the other hand, the specific doubling rate for S. avermitilis as a result of the analyses performed was 35 to 62 h, which is equivalent to 1.47 to 2.62 days.
4.5. Secondary Metabolites of Streptomyces avermitilis with Biosynthetic Potential
The production of secondary metabolites in S. avermitilis is abundant, but the full bioactive potential and the conditions under which they can occur are still unknown. When nutritional resources are limited [54], they produce the aerial filamentous hyphae where the spores are found, and they withstand adverse conditions (environmental fluctuations or laboratory-induced aspects). The spores, through some stimulus (such as light control), are released at the right time to begin BGC activation [11,52]. Previously, it has been shown that the growth and development of Streptomyces cells and the synthesis of secondary metabolites require a balanced ratio of carbon, nitrogen and phosphorus (3:1:2).
In addition, in Microbiology the production of diffusible pigments by S. avermitilis serves as a form of species identification, proof of quality and specificity of the culture medium for isolation, and as a response mechanism to form biologically active compounds (drugs). It should be noted that these depend on two factors: (1) season of the year (different climatic conditions) and (2) type of sample where the isolate was obtained [5,7,25,31,38,49].
In more advanced disciplines, such as molecular biology, it has been found that the production of first-order secondary metabolites, such as diffusible pigments, filamentous hyphae and spores, is a consequence of five biosynthetic pathways: the glucose pathway, polyketide pathway, amino acid pathway, shikimate pathway and mevalonate pathway (MVA) or methylerythritol phosphate (MEP) [31,38,39,48].
4.6. Perspectives Futures
Specifically, S. avermitilis has been shown to have a wide capacity for the production of secondary metabolites in vitro. It is a species that has a complex metabolism and is interesting to study, so below are some future perspectives that will be taken up by the authors to explore this species.
- Genomics: This research is part of the first part of a study on S. avermitilis; therefore, the authors will continue to analyze the genetic and molecular diversity of the species with a greater availability of time and reagents. With new advances in the next-generation technologies used in DNA sequencing, new and accurate data can be obtained on the identification and characterization of the metabolism of S. avermitilis.
- Metagenomics: This analysis will be used in order to provide a greater and more accurate understanding of what happens in the fermentation broth of S.avermitilis. By performing this analysis, it is possible to verify exactly what happens to the biosynthetic pathways of the species when the production of Ivermectin and diffusible pigments begins.
- Evaluation of a seasonal dynamic: The authors have the goal of conducting a study on how the climatic conditions in the area over several years intervene in the establishment of characteristics of the metabolism of S. avermitilis.
Due to the specific time and administrative resources that were required to achieve these significant advances on S. avermitilis, the points described above were not presented. For this reason, work continues on this line of research to present a more complete and in-depth analysis with the analyses that are planned to be carried out. This research can provide and improve data about the metabolism of S. avermitilis.
5. Conclusions
The bacterial metabolism of S. avermitilis varied according to the season, as it tends to be more active in some seasons of the year. This was due to the fact that S. avermitilis responds differently to the climatic conditions of each season of the year. Due to this, the isolates in vitro presented the diffusible pigments white, yellow, orange, red and pink in higher proportions in the spring and summer compared to in the autumn and winter. For the analysis of the morphological variables of S. avermitilis in vitro, it is recommended to use the ISP-3 oatmeal agar culture medium supplemented with 1% nystatin as a specific culture medium. With these conditions already established, the isolates in the summer presented the three phases of bacterial growth: lag (24 h), exponential (48–96 h) and stationary (120–168 h), with a doubling time of 35.30 to 62.92 h. The same pattern of behavior was established for the production of Ivermectin, since the highest production was quantified in the summer season with 820.71 μg mL−1.
Author Contributions
Conceptualization, J.L.M.; methodology, J.L.M., M.M.C.G. and E.M.C.G.; formal analysis, M.M.C.G., L.H.V.H., M.T.S.-T.E., C.C.R. and R.D.A.M.; research, J.L.M., M.M.C.G., E.M.C.G., L.H.V.H., M.T.S.-T.E., C.C.R. and R.D.A.M.; drafting and preparation of the original draft, J.L.M.; writing, proofreading and editing, M.M.C.G., E.M.C.G., L.H.V.H., M.T.S.-T.E., C.C.R. and R.D.A.M.; supervision, M.M.C.G. and E.M.C.G.; project management, J.L.M., M.M.C.G. and E.M.C.G. All authors have read and agreed to the published version of the manuscript.
Funding
The funding was awarded in the form of a scholarship for graduate studies in Mexico by the Ministry of Sciences, Humanities, Technology and Innovation (SECIHTI) with the CVU number 1299934.
Data Availability Statement
The raw data that support the conclusions of this article will be available in the repository Open Access documents from the Colegio de Postgraduados http://colposdigital.colpos.mx:8080/xmlui/ (accessed on 2 July 2024).
Acknowledgments
This research is part of the master’s work of the first author. We would also like to thank the Ministry of Sciences, Humanities, Technology and Innovation (SECIHTI), Mexico and the Graduate School, Montecillo Campus, for the facilities provided in the realization of the project. To the Postgraduate Degree in Genetic Resources and Productivity-Livestock (PREGEP-Livestock, Montecillo Campus) and to the line of generation and application of knowledge: “Efficient livestock, sustainable well-being and climate change”.
Conflicts of Interest
The authors declare that they have no conflicts of interest. Funders were not involved in the study design of this research, the collection, analysis, or interpretation of the data, the writing of the manuscript, or the decision to publish the results.
Abbreviations
The following abbreviations are used in this manuscript:
| S. avermitilis | Streptomyces avermitilis |
| LM | Macrocyclic lactone |
| ISP | International Streptomyces Project |
| CTS | Trypticacasein broth |
| BGC | Biosynthetic gene group |
| MVA | Mevalonate Pathway |
| MEP | Methylerythritol phosphate |
| UI | International Units |
| PNK | Polyketide synthase |
| Td | Doubling Time |
| In | Natural logarithm |
References
- Khadayat, K.; Sherpa, D.D.; Malla, K.P.; Shrestha, S.; Rana, N.; Marasini, B.P.; Khanal, S.; Rayamajhee, B.; Bhattarai, B.R.; Parajuli, N. Molecular identification and antimicrobial potential of Streptomyces species in Nepalese soil. Int. J. Microbiol. 2020, 2020, 8817467. [Google Scholar] [CrossRef] [PubMed]
- Waksman, S.A.; Henrici, A.T. The nomenclature and classification of actinomycetes. J. Bacteriol. 1943, 46, 337–341. [Google Scholar] [CrossRef] [PubMed]
- Singh, V.; Haque, S.; Singh, H.; Verma, J.; Vibha, K.; Singh, R.; Jawed, A.; Tripathi, C.K.M. Isolation, screening and identification of new actinomycete isolates from India for antimicrobial applications. Front. Microbiol. 2016, 7, 1921. [Google Scholar] [CrossRef]
- Davis, K.E.; Joseph, S.J.; Janssen, P.H. Effects of growth medium, inoculum size, and incubation time on the cultivability and isolation of soil bacteria. Appl. Environ. Microbiol. 2005, 71, 826–834. [Google Scholar] [CrossRef] [PubMed]
- Siddique, S.; Syed, Q.; Adnan, A.; Qureshi, F.A. Isolation, characterization and selection of avermectin-producing strains of Streptomyces avermitilis from soil samples. Jundishapur J. Microbiol. 2014, 7, e10366. [Google Scholar] [CrossRef]
- Tian, J.; Li, Y.; Zhang, C.; Su, J.; Lu, W. Characterization of a pleiotropic regulator, MtrA, in Streptomyces avermitilis, which controls avermectin production and morphological differentiation. Made Microb. Cells 2024, 23, 103. [Google Scholar] [CrossRef]
- Xue, L.; Xue, Q.; Chen, Q.; Lin, C.; Shen, G.; Zhao, J. Isolation and evaluation of actinomycetes from the rhizosphere with potential application for biocontrol of cotton Verticillium wilt. Crop Prot. 2013, 43, 231–240. [Google Scholar] [CrossRef]
- Condori, P.S.J.; Fernandez, G.P.R.; Valderrama, V.M.R. Isolation and characterization of Streptomyces spp rizospheres promoters of vegetable growth. Idesia (Arica) 2019, 37, 109–116. [Google Scholar] [CrossRef]
- Zhu, J.; Chen, Z.; Li, J.; Wen, Y. AvaR1, a butenolide-like autoregulatory receptor in Streptomyces avermitilis, directly represses avenolide and avermectin biosynthesis and multiple physiological responses. Front. Microbiol. 2017, 8, 2577. [Google Scholar] [CrossRef]
- Porter, J.N.; Wilhelm, J.J.; Tresner, H.D. Method for preferential isolation of actinomycetes from soils. Appl. Microbiol. 1960, 8, 174–178. [Google Scholar] [CrossRef]
- Lechevalier, H.A.; Williams, S.T.; Sharpe, M.E.; Holt, J.G. Actinomycetes: A Practical Guide to the Genetic Identification of Actinomycetes. In Bergey Manual of Systematic Bacteriology; Springer: Berlin/Heidelberg, Germany, 1989; pp. 2344–3330. [Google Scholar]
- El Karkouri, A.; Assou, S.A.; El Hassouni, M. Isolation and screening of antimicrobial substance-producing actinomycetes from an extreme Moroccan biotope. Pan-Afr. Med. J. 2019, 33, 329. [Google Scholar] [CrossRef] [PubMed]
- Siddique, S.; Syed, Q.; Adnan, A.; Nadeem, M.; Irfan, M.; Ashraf, Q.F. Production of avermectin B1b from Streptomyces avermitilis 41445 by submerged batch fermentation. Jundishapur J. Microbiol. 2013, 6, e7198. [Google Scholar] [CrossRef]
- Shepherd, M.D.; Kharel, M.K.; Bosserman, M.A.; Rohr, J. Laboratory maintenance of Streptomyces sp. Curr. Protoc. Microbiol. 2010, 10, 10E.1. [Google Scholar] [CrossRef]
- Feeney, M.; Duncan, R.K.; Fernandez, M.L.; Hutchings, M. ActinoBase: Tools and protocols for researchers working with Streptomyces and other filamentous actinobacteria. Microb. Genom. 2022, 8, 000824. [Google Scholar] [CrossRef]
- Shirling, E.B.; Gottlieb, D. Methods for the characterization of Streptomyces species. Int. J. Syst. Bacteriol. 1966, 16, 313–340. [Google Scholar] [CrossRef]
- Anwar, S.; Ali, B.; Sajid, I. Screening of rhizospheric actinomycetes for various plant growth-promoting traits (PGPs) in vitro and in vivo and for agroactive compounds. Front. Microbiol. 2016, 7, 1334. [Google Scholar] [CrossRef]
- Rojas, T.A. Concepts and Practice of General Microbiology. Universidad Nacional de Colombia, Campus Palmira 2011. pp. 49–55. Available online: https://repositorio.unal.edu.co/handle/unal/8391 (accessed on 28 June 2025).
- Reiner, K. Catalan Test Protocol. American Society for Microbiology. 2010, pp. 1–9. Available online: https://asm.org/protocols/catalase-test-protocol (accessed on 2 May 2024).
- Bartolomé, J.W.; Mittwer, T. Gram staining. Bacteriol. Rev. 1952, 16, 1–29. [Google Scholar] [CrossRef]
- Kampfer, P. Streptomyces Waksman and Henrici 1943, 339AL. In Bergey’s Manual of Systematic Bacteriology; Goodfellow, M., Kampfer, P., Busse, H.J., Trujillo, M., Suzuki, K.E., Ludwig, W., Whitman, W.B., Eds.; Springer: New York, NY, USA, 2012; Volume 5, pp. 1455–1481. Available online: https://link.springer.com/book/10.1007/978-0-387-68233-4 (accessed on 30 April 2024).
- Hopwood, D.A. Highlights of Streptomyces genetics. Herencia 2019, 123, 23–32. [Google Scholar] [CrossRef]
- Burg, R.W.; Miller, B.M.; Baker, E.E.; Birnbaum, J.; Currie, S.A.; Hartman, R.; Kong, Y.L.; Monaghan, R.L.; Olson, G.; Putter, I. Avermectins, a new family of potent anthelmintic agents: Producing organism and fermentation. Antimicrob. Agents Chemother. 1979, 15, 361–367. [Google Scholar] [CrossRef]
- Kim, S.B.; Goodfellow, M. Streptomyces avermitilis sp. nov., nom. rev., a taxonomic home for avermectin-producing Streptomycetes. Int. J. Syst. Evol. Microbiol. 2002, 52, 2011–2014. [Google Scholar] [CrossRef]
- Ikeda, H.; Ishikawa, J.; Hanamoto, A.; Shinose, M.; Kikuchi, H.; Shiba, T.; Sakaki, Y.; Hattori, M.; Omura, S. Complete genome sequence and comparative analysis of the industrial microorganism Streptomyces avermitilis. Nat. Biotechnol. 2003, 21, 526–531. [Google Scholar] [CrossRef] [PubMed]
- Waksman, S.A.; Woodruff, H.B. Actinomyces antibioticus, a novel soil organism antagonistic to pathogenic and non-pathogenic bacteria. J. Bacteriol. 1941, 42, 231–249. [Google Scholar] [CrossRef]
- Takahashi, Y.; Matsumoto, A.; Seino, A.; Ueno, J.; Iwai, Y.; Omura, S. Streptomyces avermectinius sp. nov., an avermectin-producing strain. Int. J. Syst. Evol. Microbiol. 2002, 52, 2163–2168. [Google Scholar] [CrossRef]
- Jones, S.; Elliot, M. Exploring the regulation of the growth and development of Streptomyces. Curr. Opin. Microbiol. 2018, 42, 25–30. [Google Scholar] [CrossRef]
- Tresner, H.D.; Backus, E.J. Color wheel system for the taxonomy of streptomycetes. Appl. Microbiol. 1962, 11. [Google Scholar] [CrossRef]
- Khan, S.; Awadhiya, P.; Patil, S.; Banerjee, T. Avermectin production by solid-state fermentation: A novel approach. Int. J. Pharm. Pharm. Sci. 2017, 9, 55–61. [Google Scholar] [CrossRef]
- Zhang, X.; Chen, Z.; Li, M.; Wen, Y.; Song, Y.; Li, J. Construction of ivermectin producer by domain swaps of avermectin polyketide synthase in Streptomyces avermitilis. Appl. Microbiol. Biotechnol. 2006, 72, 986–994. [Google Scholar] [CrossRef] [PubMed]
- Mohamed, M.A.; Awad, H.M. Novel lipase-producing Streptomyces isolated from the Haloalkaline habitat of Wadi El Natrun: Polyphase identification and statistical optimization of enzyme production. Beni-Suef Univ. J. Basic Appl. Sci. 2021, 10. [Google Scholar] [CrossRef]
- Undabarrena, A.; Ugalde, J.A.; Seeger, M.; Cámara, B. Genomic data mining of the marine actinobacterium Streptomyces sp. H-KF8 reveals information about genes related to multiple stress and metabolic pathways involved in antimicrobial synthesis. PeerJ 2017, 5, e2912. [Google Scholar] [CrossRef]
- Del Carratore, F.; Hanko, E.R.; Breitling, R.; Takano, E. Biotechnological application of Streptomyces for the production of clinical drugs and other bioactive molecules. Curr. Opin. Biotechnol. 2022, 77. [Google Scholar] [CrossRef] [PubMed]
- Goswami, S.; Nagarajan, K.; Goel, R.; Dixit, K.P.; Saxena, V.; Kumar, C.S.; Kumar, V. Development of analytical methods and validation parameters of Ivermectin drugs: Pharmaceutical sciences and related sciences. Int. J. Life Sci. Pharm. Res. 2022, 12, 1–12. [Google Scholar] [CrossRef]
- Taspinar, N. Comparison with spectrophotometric and liquid chromatography methods of pharmaceutical forms of ivermectin. Med. Rec. 2023, 5, 126–131. [Google Scholar] [CrossRef]
- Donald, L.; Pipite, A.; Subramani, R.; Owen, J.; Keyzers, R.A.; Taufa, T. Streptomyces: Still the largest producer of new natural secondary metabolites: A current perspective. Microbiol. Res. 2022, 13, 418–465. [Google Scholar] [CrossRef]
- Nepal, K.; Wang, Q. Streptomycetes: Surrogate hosts for genetic manipulation of biosynthetic gene clusters and the production of natural products. Adv. Biotechnol. 2019, 37, 1–20. [Google Scholar] [CrossRef]
- Lee, N.; Hwang, S.; Lee, Y.; Cho, S.; Palsson, B.; Cho, B.K. Synthetic biology tools for the discovery of novel secondary metabolites in Streptomyces. J. Microbiol. Biotechnol. 2019, 29, 667–686. [Google Scholar] [CrossRef] [PubMed]
- Guo, J.; Ma, R.; Su Bo, S.; Long, L.Y.; Zhang, J.; Fang, J. Increasing avermectin production in Streptomyces avermitilis by using 831 nanosecond pulsed electric fields (nsPEF). Sci. Rep. 2016, 6, 25949. [Google Scholar] [CrossRef] [PubMed]
- Patel, J.K.; Patel, N.K. RP-HPLC stability indicator method for the determination of ambrisentan and tadalafil in pharmaceutical form. Sci. Pharm. 2014, 82, 749–764. [Google Scholar] [CrossRef]
- Waldia, A.; Gupta, S.; Issarani, R.; Prakash, N.B. Validated liquid chromatographic method for simultaneous estimation of albendazole and ivermectin in tablet dosing form. Indian J. Chem. Technol. 2008, 15, 617–620. Available online: https://www.researchgate.net/publication/279712853_Validated_liquid_chromatographic_method_for_simultaneous_estimation_of_albendazole_and_ivermectin_in_tablet_dosage_form/citations (accessed on 2 July 2024).
- Sigma Aldrich®. Certificate of Analysis-Certified Reference Material: Ivermectin, Supelco. 2023. Available online: https://www.sigmaaldrich.com/certificates/Graphics/COfAInfo/fluka/pdf/rtc/PHR1380_LRAD6625.pdf (accessed on 2 July 2024).
- Crump, A.; Ōmura, S. Ivermectin ‘miracle drug’ from Japan: The perspective of human use. Proc. Acad. Jpn. Ser. B Phys. Biol. Sci. 2011, 87, 13–28. [Google Scholar] [CrossRef] [PubMed]
- Ampuero, A.; Rojas, R.; Ruiz, C.; Hurtado, J. Antimicrobial activity of Streptomyces sp. 6E3 isolated from mineral concentrate. Peruv. J. Exp. Med. Public Health 2020, 37, 110–114. [Google Scholar] [CrossRef]
- Chen, Z.; Song, Y.; Wen, Y.; Li, J. Effect of gene disruption of aveD on avermectins production in Streptomyces avermitilis. Wei Sheng Wu Xue Bao Acta Microbiol. Sin. 2001, 41, 440–446. Available online: https://pubmed.ncbi.nlm.nih.gov/12552909/ (accessed on 30 July 2024).
- Liu, Q.; Xiao, L.; Zhou, Y.; Deng, K.; Tan, G.; Han, Y.; Liu, X.; Deng, Z.; Liu, T. Development of Streptomyces sp. FR-008 as a pop-up chassis. Synth. Syst. Biotechnol. 2016, 1, 207–214. [Google Scholar] [CrossRef]
- Komatsu, M.; Komatsu, K.; Koiwai, H.; Yamada, Y.; Kozone, I.; Izumikawa, M.; Hashimoto, J.; Takagi, M.; Omura, S.; Shin-ya, K.; et al. Engineered Streptomyces avermitilis host for heterologous expression of biosynthetic gene cluster for secondary metabolites. ACS Synth. Biol. 2013, 2. [Google Scholar] [CrossRef]
- Cuervo, L.; Álvarez, G.S.; Salas, J.A.; Méndez, C.; Olano, C.; Malmierca, M.G. The volatile organic compounds of Streptomyces spp.: An in-depth analysis of their antifungal properties. Microorganisms 2023, 11, 1820. [Google Scholar] [CrossRef]
- Balows, A.; Murray, P.R.; Baron, E.J.; Jorgenson, J.H.; Pfaller, M.A.; Yolken, R.H. Manual of Clinical Microbiology 8th edition. Diagn. Microbiol. Infect. Dis. 2003, 47, 625–626. [Google Scholar] [CrossRef]
- Li, M.Q.; Bi, Z.; Xie, L.J.; Sun, G.; Liu, Z.; Kong, Q.; Wei, X.; Chen, C.M. From starch to carbon materials: Perspectives on the crosslinking reaction and its influence on the carbonization process. ACS Sustain. Chem. Eng. 2019, 7, 14796–14804. [Google Scholar] [CrossRef]
- Gao, H.; Liu, M.; Liu, J.; Dai, H.; Zhou, X.; Liu, X.; Zhuo, Y.; Zhang, W.; Zhang, L. Optimization of the medium for the production of avermectin B1a by Streptomyces avermitilis 14-12A using the response surface methodology. Biol. Resour. Technol. 2009, 100, 4012–4016. [Google Scholar] [CrossRef] [PubMed]
- Kumar, P.; Dubey, K.K. Modulation of fatty acid metabolism and tricarboxylic acid cycling to enhance lipsstatin production through media engineering in Streptomyces toxytricini. Biol. Resour. Technol. 2016, 213, 64–68. [Google Scholar] [CrossRef]
- Chen, L.; Cui, H.; Su, C.; Bai, F.; Zhao, X. The analysis of the complete genome sequence of a strain of marine origin Streptomyces sp. S063 CGMCC 14582 reveals its biosynthetic potential to produce novel anti-complement agents and peptides. PeerJ 2019, 7, e6122. [Google Scholar] [CrossRef]
Disclaimer/Publisher’s Note: The statements, opinions and data contained in all publications are solely those of the individual author(s) and contributor(s) and not of MDPI and/or the editor(s). MDPI and/or the editor(s) disclaim responsibility for any injury to people or property resulting from any ideas, methods, instructions or products referred to in the content. |
© 2025 by the authors. Licensee MDPI, Basel, Switzerland. This article is an open access article distributed under the terms and conditions of the Creative Commons Attribution (CC BY) license (https://creativecommons.org/licenses/by/4.0/).